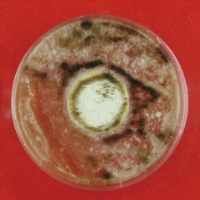

高耐候性


劣化要因に耐性を発揮する独自技術により、高耐候性を発揮。塗膜の劣化要因である紫外線・雨による影響を受けにくく、建物を長期間保護します。

※あくまで試験環境下における推測値であり、耐候性を保証するものではありません。実際の自然ばく露環境下では、下地の状態、施工方法、気象条件により耐候性は異なる場合があります。
超低汚染プラチナリファイン2000 Si-IR
促進耐候性試験(キセノンランプ式)において
約16~19年相当※経過後も光沢保持率80%以上を保持
※期待耐用年数
「高耐候性」を実現する
超低汚染プラチナリファインの技術

劣化に強い無機成分を豊富に配合
一般的なシリコン塗料と比較して、劣化に強い「無機成分」を豊富に配合。樹脂同士が強固に結びつき、緻密で強靭な塗膜を形成するため、紫外線に対して優れた耐候性を発揮。
無機成分とは
紫外線により分解されない性質を持つ物質。劣化に強い「ガラス」は無機成分を主成分とする物質。

劣化要因”ラジカル”を抑える技術により耐候性のさらなる向上を実現
ラジカルとは、塗料に色を付ける顔料の主成分である「酸化チタン」が、紫外線の影響を受けることで発生する劣化因子です。このラジカルが発生すると、樹脂の結合が破壊され、塗膜の劣化が進行してしまいます。
-

ラジカル制御型
白色顔料ラジカルが発生しにくく、ラジカルが発生した場合にもシールド層がラジカル放出を防ぐため、樹脂の破壊を抑える。
-

ラジカルを捕捉
する「HALS」※「ラジカル」を捕捉する「HALS(光安定剤)」を配合。ラジカル制御型白色顔料の補完として、ラジカルによる塗膜劣化を抑制する。
※HALS:Hindered Amine Light Stabilizer(光安定剤)
超低汚染性
最高水準の“超”低汚染性を発揮

屋外暴露雨筋試験/1年経過後比較

無機成分の配合により緻密で強靭な塗膜を形成。他社と比較しても、汚れの付着・定着を抑え、長期間にわたり、美観を維持します。

-
緻密性
無機成分配合により、緻密で強靭な塗膜を形成。粒子の細かい汚染物質も突き刺さりにくく、美観を維持。

-
親水性
親水性 (水になじみやすい性質)により、塗膜に汚れが付着しても、汚れの間に水が入り込み、汚れを洗い流す。

防カビ・防藻性
美観維持に貢献

-
カビ
培養4週間後の様子

汎用塗料 
超低汚染プラチナ
リファイン -
藻
培養4週間後の様子

汎用塗料 
超低汚染プラチナ
リファイン
「JIS Z 2911 かび抵抗性試験⽅法」および「藻抵抗性試験(社内試験による)」に合格。
通常配合されている防カビ・防藻剤に加えて、効果を高める薬剤を配合。より多くの種類の菌種に対して、効果を発揮し、防カビ・防藻性を長期間維持します。
遮熱性

-
一般的な塗料

近赤外線の熱を吸収
-
超低汚染プラチナリファインシリーズ

近赤外線の熱を効果的に反射
太陽光の波長のうち温度上昇の原因となる近赤外線を効果的に反射する塗膜を形成。
室内の温度上昇を抑えます。(※2)
※1アステック標準色8113トゥルーホワイト以外の全色で使用。
※2建物構造、断熱構造、開口部(ガラス窓)の大きさ・数によって温度変化の程度に差が出ます。
遮熱性比較試験
塗料を塗布したサイディングに約1時間ランプ照射し、塗膜の表面温度を測定。一般的な塗料と比較して、約13.1℃の温度差があり、優れた遮熱性を発揮することが確認された。


遮熱保持性

-
一般的な塗料

付着した汚れが熱を吸収し、
徐々に遮熱性能が低下する -
超低汚染プラチナリファインシリーズ

汚れが付着しにくいため熱の吸収を防ぎ、
遮熱性を長期間保持する
一般の遮熱塗料は、経年とともに付着した汚れが熱を吸収するため、徐々に遮熱効果が低下していきます。
超低汚染プラチナリファインシリーズは美しさが長く続くため、汚れによる熱の吸収を抑制。一般的な遮熱塗料に比べて長く遮熱効果を発揮します。
超低汚染プラチナリファイン2000Si-IR
水性形二液外壁用低汚染遮熱シリコン系上塗材

製品データ
| 荷姿 | 16kgセット(A液:15kg、B液:1kg) |
|---|---|
| 3.2kgセット(A液:3kg、B液:0.2kg) | |
| 塗布量 | 0.30~0.40kg/㎡ |
| 希釈 | ローラーの場合:0~5%(清水) |
| エアレスの場合:5~10%(清水) | |
| 艶 | 艶有、3分艶 |
| 色 | アステック標準色68色 |
| 可使時間 | 4時間以内(25℃)、2時間以内(35℃) |
対応素材
窯業系サイディング・モルタル・ALC・コンクリート・金属サイディング(カラー鋼板 ※1・ガルバリウム鋼板・ステンレス・アルミニウム)・波形スレート(外壁) ※2・各種旧塗膜※1:フッ素鋼板は除く ※2:高圧洗浄有り
試験結果
- JIS A 6909 建築用仕上塗材
- 『可とう性』
- 合格
- JIS K 5658 建築用耐候性上塗り塗料
- 『容器の中の状態』『表面乾燥性』『塗膜の外観』『ポットライフ』『隠ぺい率』『鏡面光沢度』『耐衝撃性』『付着性(クロスカット法)』『重ね塗り適合性』『耐アルカリ性』『耐酸性』『耐湿潤冷熱繰返し性』
- 全て合格
- 防カビ性
- ※社内試験による(参考試験方法:JIS Z 2911 かび抵抗性試験方法)
- 合格
- 防藻性
- ※社内試験による
- 合格
お問い合わせはお気軽に!
ご都合にあわせてお問い合わせ方法をお選びください。
[
ピックアップ
]

 0120-000-000
0120-000-000